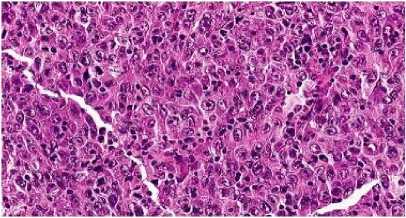

PROFIL PENDERITA KANKER NASOFARING DI RUMAH SAKIT UMUM PUSAT SANGLAH DENPASAR PERIODE JANUARI – DESEMBER TAHUN 2014
on
ISSN: 2303-1395 E-JURNAL MEDIKA, VOL. 8 NO.2,Februari, 2019
Il—∖γλ λ ∣directoryof
OPEN ACCESS I —∖U JOURNALS
PROFIL PENDERITA KANKER NASOFARING DI RUMAH SAKIT UMUM PUSAT SANGLAH DENPASAR PERIODE JANUARI – DESEMBER TAHUN 2014
Putu Diva Dharma Suta1, Komang Andi Dwi Saputra2Sari Wulan Dwi Sutanegara2 1Program Studi Pendidikan Dokter 2Bagian/SMF Telinga Hidung Tenggorokan
Fakultas Kedokteran Universitas Udayana Email: divadsuta@ymail.com
ABSTRAK
Karsinoma nasofaring adalah tumor ganas yang berasal dari epitel nasofaring, tumbuh dari fossa Rosenmüller dan dapat meluas hingga ke hidung, tenggorok, serta dasar tengkorak.Etiologi dari kanker nasofaring adalah infeksi dari virus Epstein-Barr, kerentanan genetik, dan paparan zat kimia atau faktor lingkungan. Tujuan dari penelitian ini adalah untuk mengetahui bagaimana profil pasien dengan penyakit KNF di Bali, dengan mengambil sampel dari data rekam medis di Poliklinik THT-KL RSUP Sanglah Denpasar. Pada penelitian ini, profil penderita karsinoma nasofaring dikelompokkan berdasarkan usia, jenis kelamin, tipe histologi, stadium penyakit, dan keluhan yang didapat dari data rekam medis. Jumlah kasus karsinoma nasofaring di RSUP Sanglah pada tahun 2014 adalah 50 kasus. Tidak ditemukan kasus pada usia 1-14 tahun, 54 % kasus ditemukan pada kelompok usia 4564 tahun dan 30 % pada kelompok usia 25-44 tahun. Sebanyak 82 % ditemukan pada laki – laki, sedangkan 18 % pada perempuan. Berdasarkan tipe histologi, tidak ditemukan pada tipe histologi Basaloid Squamous Cell Carcinoma, 84 % pada Undifferentiated Cell Carcinoma dan 14 % pada tipe histologi Non Keratinizing Squamous Cell Carcinoma. Berdasarkan stadium penyakit, ditemukan 40 % pada stadium IV C, 34 % pada stadium IV B, 16 % pada stadium III, 8% pada stadium IV A, 2 % pada stadium II B, dan tidak ditemukan pada stadium I dan II A. Dilihat dari keluhan didapatkan 48 % mengalami keluhan berupa benjolan pada leher, 34 % lemas, mual, dan nyeri pada leher, 18 % keluhan lain berupa nyeri ulu hati, mual, muntah, sesak serta batuk.
Kata kunci: Nasofaring, Etiologi, Keluhan.
Il--∖(—∖ Λ i DIRECTORY OF OPEN ACCESS I—V√ JOURNALS
ABSTRACT
Nasopharyngeal carcinoma including into one of malignant tumor that is derived from nasopharyngeal epithelial malignant tumor that usually grows from fossa Rosenmuller and may extend to the nose, throat, and base of the skull. Etiology of nasopharyngeal cancer including infection of the Epstein-Barr virus, susceptibility of the genetic, and chemicals or environmental exposure. This study aimed to determine how the profile of nasopharyngeal carcinoma patients in Bali, so that the researcher took sample of medical in Poliklinik THT-KL RSUP Sanglah Denpasar. This research classified the profile of nasopharyngeal carcinoma patients according to age, gender, histological type, stage of disease, and complaints which were obtained from medical records. The number of cases nasopharyngeal carcinoma in RSUP Sanglah on 2014 are 50 cases. No cases at the age of 1-14 y.o, 54% of cases are found in the group age 45-64 y.o and 30% in the group age 25-44 y.o. A total of 82% cases were found in men, while 18% cases were found in women. Based on histological type, no case was found in Basaloid Squamous Cell Carcinoma, 84% in Undifferentiated Cell Carcinoma and 14% in Non keratinizing Squamous Cell Carcinoma. Based on the stage of the disease, 40% in stage IV C, 34% in stage IV B, 16% in stage III, 8% in stage IV A, 2% in stage II B, and no case was found in stage I and II A. Based on complaints,there was 48% patients had complaints of a lump in the neck, 34% fatigue, nausea, and pain in the neck, 18% consisted of other various complaints such as tightness, coughing, epigastric pain, nausea and vomiting.
Keywords: Nasopharynx, Etiology, Symptoms
ISSN: 2303-1395
I--∖(—∖ Λ i DIRECTORY OF OPEN ACCESS I—V√ JOURNALS
PENDAHULUAN
Karsinoma nasofaring (KNF) merupakan tumor ganas yang paling banyak dijumpai dalam bidang THT di Indonesia yang dapat mengenai semua golongan umur. Secara umum, KNF berhubungan erat dengan infeksi virus Ebstein-Barr (EBV).1,2
Menurut survei epidemiologi, insiden KNF tertinggi terdapat di negara Cina bagian selatan, dimana mencapai 25 orang pada100.000 penduduk setiap tahunnya. Sebuah penelitian di Makaupada tahun 2009 menemukan kanker nasofaring menduduki urutan kelima kanker tersering pada pria dan pada urutan kesembilan pada wanita. Angka insiden dan kematian oleh karena kanker nasofaring sebesar 15,5 dan 11,3 masing-masing. Angka insiden pada pria dan wanita masing-masing 5,4 dan 0,4 per 100.000 orang.3Sebagian besar penderita KNF berusia diatas 20 tahun, dan dengan usia terbanyak adalah antara 50 hingga 70 tahun. Sebanyak 2% penderita KNF merupakan anak-anak, dan hal senada ditemukan di Guangzhou, dimana sebanyak 1% penderita KNF berusia dibawah 14 tahun. Penelitian lain di Medan menyebutkan bahwa kelompok usia terbanyak untuk KNF adalah 50 hingga 59 tahun, sebesar 29,1%. Umur penderita termuda yaitu 21 tahun dan
tertua 77 tahun, dengan rerata usia 48,8 tahun.4
Hingga saat ini, etiologi yang dikenal sebagai penyebab dari KNF yaitu infeksi virus Epstein-Barr, kerentanan genetik serta paparan zat kimia atau faktor lingkungan.5,6Hubungan antara infeksi virus Epstein-Barr dengan kejadian KNF telah dibuktikan dengan beberapa temuan hingga saat ini, yang mencakup: (1) titer antibodi IgA terhadap EBV pada kebanyakan penderita karsinoma nasofaring lebih tinggi dibandingkan dengan kontrol normal serta penderita kanker lainnya; (2) pada pasien dengan tumor yang besar, memiliki titer IgA antibodi terhadap EBV yang lebih tinggi; (3) ditemukannya DNA atau RNA dari EBV pada hampir semua sel KNF; (4) ditemukannyaEBV dalam bentuk episomal klonal, menunjukkan bahwa virus telah berada di dalam sel tumor sebelum ekspansi klonal; (5) ditemukannyaEBV dalam lesi prekursor KNF, tetapi tidak pada epitel nasofaring normal. Berdasarkan bukti tersebut, International Agency for Research on Cancer (IARC) menyimpulkan jika EBV merupakan agen karsinogenik yang terlibat dalam patologi KNF.5
DOAJ
DIRECTORY OF OPEN ACCESS JOURNALS
Selain infeksi dari virus Epstein-Barr sendiri, interaksinya dengan perubahan genetik yang terjadi mencetuskan perubahan dari sel epitel nasofaring menjadi ganas. Pada semua sel KNF undifferentiated dan displastik terdeteksi adanya genom EBV, namun jarang ditemukan di dalam sel-sel epitel nasofaring normal yang berdekatan. Ekspresi gen EBV laten (misalnya EBNA 1, LMP1, LMP2) dapat mengubah beberapa jalur transduksi sinyal dan dengan demikian memberikan kontribusi pada transformasi epitel nasofaring.7
Faktor lingkungan juga memiliki peran dalam meningkatnya kejadian KNF. Pola diet masyarakat pesisir pantai, yang didukung dengan kurangnya keadaan sosio-ekonomi cenderung membuat mereka lebih banyak mengkonsumsi ikan asin atau daging asin oleh karena harganya yang lebih terjangkau. Konsumsi ikan asin dalam jangka waktu panjang akan menyebabkan penumpukan nitrosamin dalam tubuh yang merupakan senyawa karsinogenik. Kurangnya sumber pangan kaya antioksidan seperti sayur dan buah-buahan juga menjadi faktor risiko munculnya keganasan.7
KNF terbentuk melalui beberapa tahap karsinogenesis, namun sirkuit yang sangat terintegrasi dan kompleks molekul
sinyal dalam patogenesis KNF belum dipahami secara seseluruhan. Adanya disregulasi dan ekspresi protein abnormal dari molekul dalam jalur sinyal tertentu yang terlibat dalam fungsi selular termasuk proliferasi, adhesi, kelangsungan hidup, dan apoptosis telah terbukti ditemukan dalam sel KNF.8
Oleh karena lokasi anatomisnya, rongga nasofaring sulit untuk dilihat sehingga tumor yang tumbuh sering tidak diketahui, ditambah hanya sedikit yang memberikan gejala pada fase awal. Seringkali penyebaran tumor ke kelenjar getah bening regional, atau yang bahkan sudah menjalar ke intrakranial masih menunjukkan gambaran mukosa nasofaring yang tampak normal. Gejala dari KNF dapat dibedakan menjadi gejala awal dan gejala lanjutan. Gejala awalmuncul pada saat tumor tumbuh masih dalam batas nasofaring, sehingga menimbulkan gejala setempat seperti tinnitus, rasa tidak nyaman ditelinga, atau pendarahan pada hidung yang terjadi berulang, sedikit-sedikit dan bercampur ingus. Sementara gejala lanjutan timbul apabila tumor berkembang keluar dari nasofaring, baik berupa infiltrasi tumor ke jaringan sekitar maupun metastasis.9Tumor dapat tumbuh ekspansif ke depan mengisi nasofaring, sehingga koana tertutup dan menyebabkan hidung tersumbat secara
I--∖(—∖ Λ i DIRECTORY OF OPEN ACCESS I—V√ JOURNALS unilateral maupun bilateral. Apabila tumbuh ke bawah, palatum mole akan terdesak sehingga timbul gangguan menelan atau sesak. Apabila tumbuh ke atas, tumor akan masuk ke intrakranial masuk ke intrakranial dan mengenai dura, sehingga menyebabkan nyeri kepala hebat, dan seringkali mengenai saraf kranial. Keluhan tersering adalah paresis saraf abdusen (N VI) dengan keluhan diplopia dan strabismus, dan paresis saraf trigeminus (N V) dengan keluhan baal di pipi dan wajah atau timbul gejala neuralgia trigeminal, biasanya secara unilateral. Bila mengenai N III dan IV akan timbul ptosis dan oftalmoplegia.10
Diagnosis KNF ditegakkan
berdasarkan anamnesis, pemeriksaan fisik dan pemeriksaan penunjang. Dari anamnesis akan didapatkan gejala nasofaring, gejala telinga, saraf maupun metastasis.4Pemeriksaan fisik yang dapat dilakukan yaitu rinoskopi posterior dengan atau tanpa menggunakan
kateter.11Endoskopi nasofaring merupakan investigasi awal pilihan untuk mendeteksi KNF, sedangkan diagnosis definitif KNF yang dikonfirmasi melalui biopsi endoskopi pada lokasi primer
tumor.12Magnetic Resonance (MR)
ditemukan lebih unggul dalam
menggambarkan metastasis, menunjukkan infiltrasi jaringan lunak dan perluasan https://ojs.unud.ac.id/index.php/eum
intrakanial. Pemeriksaan serologi IgA terhadap virus kapsid antigen (VCA) dan IgG / IgA terhadap antigen awal (EA) adalah yang paling banyak digunakan sebagai alat diagnostik, dengan tingkat deteksi yang dilaporkan untuk NPC bervariasi 69-93%.5
Klasifikasi karsinoma nasofaring berdasarkan WHO secara garis besar dibagi menjadi dua: (1) Karsinoma sel skuamosa berkeratin. Pada KNF tipe ini terlihat gambaran diferensiasi skuamous disertai intercellular bridges, serta keratin dalam gambaran histologinya; (2)Karsinoma sel skuamosa tidak berkeratinyang mencakup tipe terdiferensiasi dan tipe tidak terdiferensiasi. Tipe tumor ini umumnya lebih radiosensitif dan mempunyai hubungan yang kuat dengan EBV. Karsinoma non-keratin tidak terdiferensiasiterdiri atas sel-sel tumor yang terdiferensiasi dengan maturasi sel skuamous. Sementarapada karsinoma yang tidak terdiferensiasi, sel-sel tumor dengan bentuk inti oval atau bulat vesikular dengan anak inti menonjol. Batas antar sel tidak jelas dan dengan hubungan antar sel yang sinsitial. Karsinoma sel skuamosa basaloid merupakan tipe histologi yang jarang, terdiri dari komponen basaloid dan komponen skuamosa.10
DIRECTORY OF OPEN ACCESS JOURNALS

Gambar 1.Karsinoma sel skuamosa

Gambar 3. Karsinoma tidak
berkeratin5

Gambar 2. Karsinoma sel skuamosa tidak
terdiferensiasi,tersusun atas sekumpulan sel yang berbentuk sarang-sarang padat (tipe Regaud).5
Gambar 4. Karsinoma tidak
berkeratin. 5
Tipe non-terdiferensiasi memiliki dua pola histologi berbeda. Tipe Regaud merupakan sekumpulan sel epiteoild berbatas tegas dengan jaringan ikat fibrosa dan sel limfosit yang mengitari. Berbeda dengan tipe Schminke yang memiliki sel epithelial neoplastik yang difus, dan diselingi dengan sel radang.4,5
terdiferensiasi terdiri atas sejumlah sel yang tumbuh membentuk gambaran syncytial yang tersusun difus (tipe Schmincke).5
Basaloid Squamous Cell
Carcinoma (BSCC) memiliki dua komponen, yaitu sel basaloiddan sel skuamosa yang tersusun dan berbatas secara jelas.Sel-sel basaloid
berukurankecil, inti hiperkromatik tanpanukleolus, dengan sedikitsitoplasma. Struktur ini tersusun solid
dengankonfigurasi lobular dan kadang disertai denganterdapatnyaperipheralpalisading.
DOAJ
DIRECTORY OF OPEN ACCESS JOURNALS
Gambar 5. Karsinoma sel skuamosa
basaloid, tersusun atas basaloid dengan pola pertumbuhan festoonin, berselang-seling dengan squamous differentiaton.5
Stagingsaat ini menggunakan sistem yang disetujui oleh UICC (Union Internationale Centre Cancer ) dan AJCC (Americant Joint Committe on Cancer), dengan pembagian sistem TNM sebagai berikut.5
Tabel 1. Stadium berdasarkan UICC dan AJCC.5
T (perluasan tumor primer, keadaan dan besarnya)
T1 Tumor primer hanya pada nasofaring
T2 Perluasan pada orofaring dan/ fossa nasal
T2a Tidak ada perluasan ke parafaring
T2b Terdapat perluasan ke parafaring
T3 Perluasan pada struktur tulang dan/
sinus paranasal
T4 Tumor menginvasi intrakranial dan/
mengenai saraf otak, fossa
infratemporal, hipofaring atau orbita N (pembesaran kelenjar limfe regional) N0 Tidak terdapat pembesaran kelenjar
N1 Kelenjar ipsilateral membesar< 6
cm
N2 Kelenjar bilateral membesar< 6 cm
N3 Kelenjar membesar> 6 cm atau
perluasan pada supraklavikula
M (metastase jauh)
M0 Tidak ada metastase jauh
M1 Terdapat metastase jauh
Tabel 2. Stadium penyakit berdasarkan sistem TNM.5
Stadium TNM
I T1, N0, M0
IIA T2a, N0, M0
IIB T1, N1, M0, T2a, N1, M0
atau T2B, N0-1, M0
III T1-2, N2, M0 atau T3, N0-2,
M0
IVA T4, N0-2, M0
IVB Tiap T, N3, M0
IVC Tiap T, Tiap N, M1
Terapi andalan saat ini dalam pengobatan KNF adalah terapi radiasi (RT). Pada KNF stadium I dilakukan RT saja, sementara RT dengan kombinasi kemoterapi dilakukan pada stadium III, IVA dan IVB. Sementara untuk stadium II dapat dilakukan kemoterapi. Pasien harus diobati dengan terapi radiasi intensitas-
I--∖(—∖ Λ i DIRECTORY OF OPEN ACCESS I—V√ JOURNALS termodulasi (IMRT). RT ditargetkan langsung ke tumor primer dan pada daerah sekitar yang berisiko untuk metastasis dari tumor itu sendiri.13
Pencegahan untuk KNF yang dilakukan hingga saat ini meliputi vaksinasi bagi penduduk dengan risiko tinggi dan pemberian informasi terkait cara pengolahan makanan. Edukasi terkait pola hidup sehat dilakukan, disamping juga mendukung keadaan sosial ekonomi yang lebih baik. Skrining dengan uji serologi IgA-anti VCA dan IgA anti EA bermanfaat untuk menemukan KNF lebih dini.14
Prognosis KNF secara umum tergantung pada pertumbuhan lokal dan metastase dari tumor tersebut. Karsinoma skuamosa berkeratin cenderung lebih agresif daripada tipe non-keratin dan non-terdiferensiasi, namunpada dua tipe yang disebutkan terakhir, metastase limfatik dan hematogen lebih sering terjadi. Prognosis buruk bila dijumpai limfadenopati, stadium lanjut, tipe histologik dari keratinizing squamous carcinoma. Penderita KNF dengan usia diatas 40 tahun, berjenis kelamin laki-laki dan ras Cina memiliki prognosis yang lebih buruk.14
potong-lintang retrospektifpada pasien karsinoma nasofaring (KNF) di RSUP Sanglah, Denpasar. Studi ini mengidentifikasi karakteristik penderita berdasarkan atas variabel berikut : jumlah penderita total, usia, jenis kelamin,tipe histologi, stadium serta keluhan.
Sampel penelitian ini merupakan seluruhpenderita baru KNFyang tercatat pada rekam medik RSUP Sanglah periode Januari hingga Desemper tahun 2014. Adapun penderitaKNFdengan rekam medis yang tidak memiliki data lengkap terkait variabel yang akan diteliti akan dieksklusi. Jumlah sampel ditentukan menggunakan teknik total sampling, yang diambil dari seluruh populasi target yaitu pasien KNF di RSUP Sanglah pada periode Januari hingga Desember 2014. Pengumpulan data dilaksanakan mulai dari bulan Maret sampai Juli 2015. Data sekunder yang telah diperoleh akan diolah dengan menggunakan aplikasi software SPSS, dan analisis hasil dilakukan secara deskriptif, yan disajikan dalam tabel distribusi proporsi dan narasi.
BAHAN DAN METODE PENELITIAN
Pada penelitian ini merupakan studi deskriptif yang menggunakan desain
DOAJ
DIRECTORY OF OPEN ACCESS JOURNALS
HASIL
Penelitian ini dilakukan pada semua penderita baru KNF yang berobat ke RSUP Sanglah Denpasar pada tahun 2014. Dikumpulkan sebanyak 50 data dari rekam medis.
Tabel 3. Distribusi Frekuensi Penderita KNF Berdasarkan Usia
Usia (thn) |
Jumlah (n) |
Presentase (%) |
1-14 |
- |
- |
15-24 |
1 |
2 |
25-44 |
15 |
30 |
45-64 |
27 |
54 |
>65 |
7 |
14 |
Jumlah |
50 |
100 |
Berdasarkan tabel diatas ditemukan bahwa berdasarkan usia, penderita karsinoma nasofaring paling banyak dijumpai pada rentang usia 45-64 tahun dengan jumlah 27 kasus (54 %).
Tabel 4. Distribusi Frekuensi Berdasarkan
Jenis Kelamin | ||
Jenis Kelamin |
Jumlah (n) |
% |
Laki – laki |
41 |
82 |
Perempuan |
9 |
18 |
Jumlah |
50 |
100 |
Tabel 4 menunjukkan bahwa proporsi penderita KNF lebih banyak berjenis kelamin laki-laki, yaitu 82 % (41 kasus).
Tabel 5. Distribusi Frekuensi Berdasarkan Gejala Klinis
Tipe Histologi |
Jumlah (n) |
% |
Karsinoma Sel Skuamosa Berkeratin |
1 |
2 |
Karsinoma Sel Skuamosa Non keratin |
7 |
14 |
Karsinoma Non-terdiferensiasi |
42 |
84 |
Karsinoma Sel Skuamosa Basaloid |
- |
- |
Jumlah |
50 |
100 |
Berdasarkan tabel 5, memperlihatkan bahwa berdasarkan tipe histologi, lebih banyak dijumpai pada tipe Undifferentiated Carcinoma yaitu 42 kasus (84 %), sedangkan paling sedikit dijumpai pada tipe KeratinizingSquamous Cell Carcinoma yaitu 1 kasus (2 %).
DOAJ
DIRECTORY OF OPEN ACCESS JOURNALS
Tabel 6. Distribusi Frekuensi Penderita
Karsinoma Nasofaring Berdasarkan
Stadium Penyakit | ||
Stadium |
Jumlah (n) |
% |
I |
- |
- |
IIA |
- |
- |
IIB |
1 |
2 |
III |
8 |
16 |
IVA |
4 |
8 |
IVB |
17 |
34 |
IVC |
20 |
40 |
Jumlah |
50 |
100 |
Berdasarkan tabel diatas
memperlihatkan bahwa berdasarkan stadium penyakit, penderita karsinoma nasofaring paling banyak mengalami stadium IV C yaitu 20 kasus (40 %) diikuti dengan stadium IV B yaitu 17 kasus (34 %), sedangkan jumlah paling sedikit stadium II B yaitu 1 kasus (2 %).
Tabel 7.Distribusi Frekuensi Penderita Karsinoma Nasofaring Berdasarkan Keluhan
Keluhan Jumlah (n) %
Utama
leher
dan nyeri pada
leher
Berdasarkan tabel diatas
memperlihatkan bahwa keluhan tersering berupa benjolan pada leher yaitu 24 kasus (48 %) diikuti dengan keluhan lemas, mual, dan nyeri pada leher yaitu 17 kasus (34 %), sedangkan paling sedikit mengalami keluhan lain berupa nyeri ulu hati, mual, muntah, sesak serta batuk yaitu 9 kasus (18 %).
PEMBAHASAN
Pada penelitian ini, penderita karsinoma nasofaring (KNF) pada rentang usia 45 hingga 64 tahun paling banyak ditemui. Sementara hasil penelitian Munir menemukanadanya peningkatan insiden setelah usia 25 tahun, dengan puncak usia40 hingga 60 tahun dengan rerata penderita berusia yaitu 48 tahun. Pada penelitian ini tidak ditemukan penderita karsinoma nasofaring pada usia 1-14 tahun. Menurut literatur, kejadian KNF pada anak-anak tergolong jarang.4
Dibandingkan perempuan, lebih banyak pasien KNF berjenis kelamin laki-laki, dengan rasio 41:9 (4,56). Hasil senada ditemukan pada penelitian sebelumnya dimana proporsi jenis kelaminlaki – laki lebih banyak daripada
OPEN ACCESS I__’ V√∕—∖U JOURNALS perempuan dengan perbandingan 5,4 dan 0,4.3American Cancer Society
menyebutkan laki-laki 2 kali lebih rentan
Berdasarkan tipe histologi, penderita KNF pada penelitian ini paling banyak dijumpai dengan tipe karsinoma non-terdiferensiasisebanyak 42 kasus (84 %) diikuti dengan karsinoma sel skuamosa non-keratin sebanyak 7 kasus (14 %).
Karsinoma sel skuamosa berkeratin paling sedikit dijumpai dengan jumlah 1 kasus (2 %). Literatur menyebutkan bahwa sebagian besar kasus karsinoma nasofaring disebabkan olehEBV. Infeksi EBV sendiri sangat berhubungan erat dengan tipe histologi karsinoma non-terdiferensiasi dan karsinoma sel skuamosa non-keratin.5
Berdasarkan stadium, KNF yang paling banyak dijumpai berada pada stadium IV sebanyak 41 kasus (stadium IV A, 4 kasus; stadium IV B, 17 kasus; stadium IV C, 20 kasus) dengan presentase 82 %, diikuti dengan stadium III dengan jumlah 8 kasus (16 %), stadium II dengan jumlah 1 kasus (2 %). Tidak terdapat KNF stadium I ditemukan. Hal senada sesuai dengan teori yang menyatakan bahwa diagnosis dini dari KNF sulit dilakukan karena tanda dan gejala awal KNF tidak spesifik, dan nasofaring merupakan area yang sulit untuk diperiksa. Sehingga KNF sering didiagnosa saat stadium lanjut dibandingkan keganasan lainnya.15
daripada wanita oleh karenalamanya paparan zat-zat karsinogen.15
Gejala KNF umumnya meliputi benjolan pada leher, bisa juga berupa keluhan mum seperti lemas dan mual, dan nyeri pada leher. Keluhan berupa benjolan pada leher merupakan yang paling banyak ditemui pada penelitian ini, yaitu sebanyak 24 kasus (48 %) dan diikuti dengan
keluhan lemas, mual, dan nyeri leher pada 17 kasus (34 %). Hal serupa juga
ditemukan pada literatur sebelumnya, dimana keluhan tersering adalah terdapat benjolan di leher, dilanjutkan dengan benjolan pada kedua sisi leher, sakit kepala, dan lemas serta mual.5Penyebaran sel kanker kanker pada kelenjar getah bening pada leher, sehingga kelenjar akan tapak membesar. Kelenjar getah bening merupakan kelenjar atau organ dengan sekumpulan sel sistem kekebalan tubuh yang jugaterdapat di seluruh tubuh.15Selain gejala tersebut, terdapat kemungkinan bahwa pasien KNF hanya mengalami gejala-gejala yang tidak spesifik pada stadium awal, dan dapat menetap dalam jangka waktu lama. Pasien datang ke rumah sakit setelah gejala-gejala ini mengganggu aktivitas harian mereka.16
SIMPULAN
ISSN: 2303-1395
I--∖(—∖ Λ i DIRECTORY OF OPEN ACCESS I—V√ JOURNALS
Dari penelitian ini, diperoleh simpulan bahwa jumlah penderita karsinoma nasofaring (KNF) di RSUP Sanglah, Denpasar pada tahun 2014 adalah sebanyak 50 orang, dengan penderita terbanyakberada pada kelompok usia 45 hingga 64 tahun. Berdasarkan jenis kelamin, penderita KNF lebih banyak adalah laki-laki. Stadium yang paling banyak dijumpai dalam penelitian ini adalah stadium IVC. Berdasarkan tipe histologi, didapatkan undifferentiated carcinomamerupakan yang paling banyak ditemui. Gejala tersering yang ditemui adalah adanya benjolan pada leher.
pihak yang telah mendukung terlaksananya penelitian ini: Instalasi Rekam Medis RSUP Sanglah, Denpasar serta reviewer yang turut memberikan koreksi hingga dipublikasikannya penelitian ini.
UCAPAN TERIMA KASIH
Ucapan terima kasih sebesar-besarnya penulis tujukan kepada seluruh
Il—∖/—∖ λ ∣directoryof
OPEN ACCESS IJOURNALS
348-karsinoma-nasofaring-kanker-tenggorok.html
-
5. Barnes, .L.,.Eveson, .JW., .Reichart, P., .& .Sidrasky, .D.
.Pathology.and.genetic.head.and.neck. tumours. .New.York: .IARC.Press, .2005.
-
6. Yan Lu dkk. Association between PIN1 promoter polymorphisms and risk of nasopharyngeal carcinoma.
DAFTAR PUSTAKA
1. DeVita Jr, V.,.Hellman, S., &
Rosenberg, S..A..Principle &
2012[diakses 27 Desember 2014].
Diunduh dari: URL:
practice.of.oncology. Edisi ke-5.
23269625
Philadelphia: Lippincott.–.Raven
Publishers,.2003.
-
2. Furie, B., Cassileth, P.A., Atkins,
M.B., &.Mayer, R.J.Clinical
hematology and oncology:
presentation, diagnosis,.and
treatment..New.York.:.Elsevier, 2003.
-
3. Xiao, G et al. Influence of gender and
7. Hon, L. B. Kemampuan sitologi
biopsi jarum halus pada servikal adenopati yang diduga metastasis
karsinoma nasofaring dalam
menentukan kejadian karsinoma
nasofaring pada periode januari –
desember 2012. Medan: USU
Repository, 2012.
age on the survival of patients with nasopharyngeal carcinoma 2014
[diakses 5Januari 2015]. Diunduh
dari: URL:
http://www.biomedcentral.com/1471-2407/13/226
4. Munir, D. Karsinoma nasofaring
8. Tulalamba, W. dan Janvilisri, T. Nasopharyngeal carcinoma signaling pathway: an update onmolecular
biomarkers. 2011[diakses 11 Januari 2015]. Diunduh dari: URL:
http://www.hindawi.com/journals/ijcb/ 2012/594681/citations/
(kanker tenggorok). USU Press Publishing2009[diakses 5Januari 2015]Diunduh dari: URL: http://usupress.usu.ac.id/terbitan2009
9. Hidayat, B.Hubungan antara gambar timpanometri dengan letak dan
stadium tumor pada penderita
karsinoma nasofaring di departemen
-
ISSN: 2303-1395
I—∖/—∖ λ ∣directoryof
OPEN ACCESS
IJOURNALS
tht-kl rsup h. adam malik medan. Medan: USU Repository, 2009.
-
10. Gurning, P. Tampilan latent membrane protein-1 (lmp1) pada sediaan sitologi kelenjar getah bening leher untuk diagnosis metastasis karsinoma nasofaring. Medan: USU Repository, 2014.
-
11. Nasution, IndahKhairani.Profil
penderitakarsinomanasofaringdi rsup. h. adam malik medan tahun 2010 – 2012. Medan: USU Repository, 2010
-
12. King.dkk..Primary.nasopharyngeal carcinoma:.diagnostic.accuracy.of.mr imaging.versus.that.of.endoscopy.and endoscopic.biopsy. Volume 258: Number.2..2011.[diakses 13 Januari
-
2015] . Diunduh dari: URL:
http://www.radiology.rsna.org/
-
13. Chan.dkk.Nasopharyngealcancer:EHN S–
ESMOESTROclinicalpracticeguidelin esfordiagnosis,treatment and follow-up.Annals.of Oncology.23.(Suppl..7): vii,.83-85, 2013.
-
14. Dharishini,P..Gambaran.karakteristikp enderita.karsinoma.nasofaring.di.ruma h.sakit.umum.pusat.haji.adam.malik,. medan.dari januari.sampai.desember 2009..Medan:.USU,.2009.
-
15. American.Cancer.Society.cancer.facts &figures2013-2014. Atlanta:
American.Cancer.Society,.2013.
-
16. Jayapalan,R..Profil.penderita karsinoma.nasofaring.di RSUP H. adam.malik.medan periode.januari.– desember.tahun.2012. .Medan: USU, 2012.
Discussion and feedback